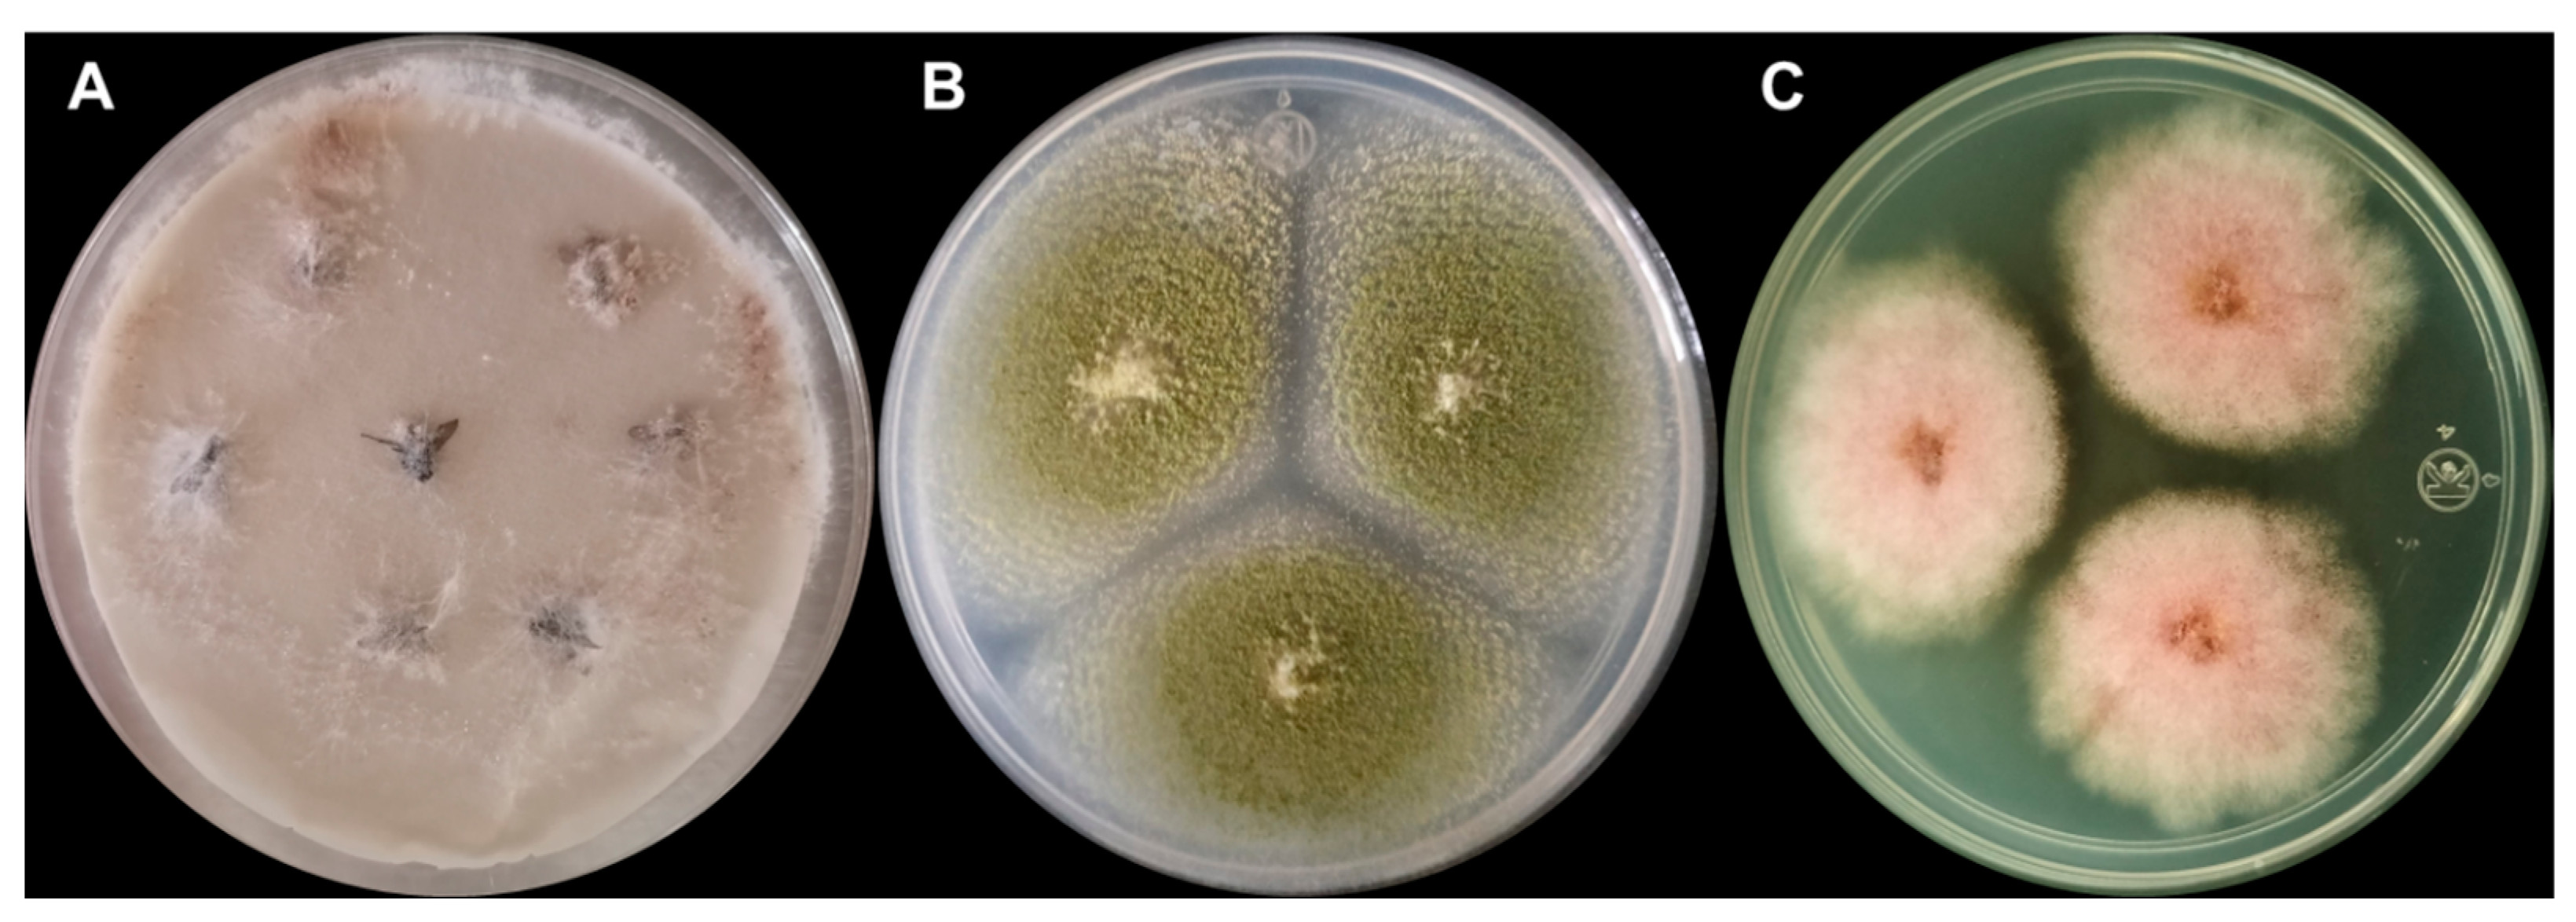
Toxins 16 00302 g002

Increased Dissemination of Aflatoxin- and Zearalenone-Producing Aspergillus spp. and Fusarium spp. during Wet Season via Houseflies on Dairy Farms in Aguascalientes, Mexico
Abstract
:1. Introduction
2. Results
2.1. Fungal Mycobiota and Housefly Population
2.2. Toxigenic Aspergillus spp. and Fusarium spp.
3. Discussion
4. Conclusions
5. Materials and Methods
5.1. Study Design
5.2. Meteorological Variables
5.3. Housefly Capture
5.4. Fungal Isolation
5.5. Quantification of Mycotoxins
5.6. Statistical Analysis
Author Contributions
Funding
Institutional Review Board Statement
Informed Consent Statement
Data Availability Statement
Acknowledgments
Conflicts of Interest
References
- Kolawole, O.; Meneely, J.; Petchkongkaew, A.; Elliott, C. A review of mycotoxin biosynthetic pathways: Associated genes and their expressions under the influence of climatic factors. Fungal Biol. Rev. 2021, 37, 8–26. [Google Scholar] [CrossRef]
- Mitchell, N.J.; Bowers, E.; Hurburgh, C.; Wu, F. Potential economic losses to the US corn industry from aflatoxin contamination. Food Addit. Contam. Part A 2016, 33, 540–550. [Google Scholar] [CrossRef]
- Grenier, B.O.I.P.; Oswald, I. Mycotoxin co-contamination of food and feed: Meta-analysis of publications describing toxicological interactions. World Mycotoxin J. 2011, 4, 285–313. [Google Scholar] [CrossRef]
- Nji, Q.N.; Babalola, O.O.; Mwanza, M. Soil Aspergillus Species, Pathogenicity and Control Perspectives. J. Fungi 2023, 9, 766. [Google Scholar] [CrossRef]
- Adelusi, O.A.; Gbashi, S.; Adebo, J.A.; Aasa, A.O.; Oladeji, O.M.; Kah, G.; Adebo, O.A.; Changwa, R.; Njobeh, P.B. Seasonal and geographical impact on the mycotoxigenicity of Aspergillus and Fusarium species isolated from smallholder dairy cattle feeds and feedstuffs in free state and Limpopo provinces of South Africa. Toxins 2023, 15, 128. [Google Scholar] [CrossRef]
- Eskola, M.; Kos, G.; Elliott, C.T.; Hajšlová, J.; Mayar, S.; Krska, R. Worldwide contamination of food-crops with mycotoxins: Validity of the widely cited ‘FAO estimate’ of 25%. Crit. Rev. Food Sci. Nutr. 2020, 60, 2773–2789. [Google Scholar] [CrossRef] [PubMed]
- Tai, B.; Chang, J.; Liu, Y.; Xing, F. Recent progress of the effect of environmental factors on Aspergillus flavus growth and aflatoxins production on foods. Food Qual. Saf. 2020, 4, 21–28. [Google Scholar] [CrossRef]
- Gallo, A.; Solfrizzo, M.E.F.; Panzarini, G.; Perrone, G. Effect of temperature and water activity on gene expression and aflatoxin biosynthesis in Aspergillus flavus on almond medium. Int. J. Food Microbiol. 2015, 18, 162–169. [Google Scholar] [CrossRef]
- Belizan, M.M.; Gomez, A.D.L.A.; Baptista, Z.P.T.; Jimenez, C.M.; Matías, M.D.H.S.; Catalán, C.A.; Sampietro, D.A. Influence of water activity and temperature on growth and production of trichothecenes by Fusarium graminearum sensu stricto and related species in maize grains. Int. J. Food Microbiol. 2019, 305, 108242. [Google Scholar] [CrossRef]
- Masigol, H.; Retter, A.; Pourmoghaddam, M.J.; Amini, H.; Taheri, S.R.; Mostowfizadeh-Ghalamfarsa, R.; Kimiaei, M.; Grossart, H.-P. Opening Pandora’s Box: Neglected biochemical potential of permafrost-associated fungal communities in a warming climate. J. Fungi 2024, 10, 20. [Google Scholar] [CrossRef]
- Medina, A.; Rodriguez, A.; Magan, N. Effect of climate change on Aspergillus flavus and aflatoxin B1 production. Front. Microbiol. 2014, 5, 103363. [Google Scholar] [CrossRef]
- Jallow, A.; Xie, H.; Tang, X.; Qi, Z.; Li, P. Worldwide aflatoxin contamination of agricultural products and foods: From occurrence to control. Compr. Rev. Food Sci. Food Saf. 2021, 20, 2332–2381. [Google Scholar] [CrossRef]
- Rangel-Muñoz, E.J.; Valdivia-Flores, A.G.; Moreno-Rico, O.; Hernández-Delgado, S.; Cruz-Vázquez, C.; De Luna-López, M.C.; Quezada-Tristán, T.; Ortiz-Martinez, R.; Máyek-Pérez, N. Characterization of Aspergillus flavus and quantification of aflatoxins in feed and raw milk of cows in Aguascalientes, Mexico. Rev. Mex. Cienc. Pecu. 2020, 11, 435–454. [Google Scholar] [CrossRef]
- Álvarez-Días, F.; Torres-Parga, B.; Valdivia-Flores, A.G.; Quezada-Tristán, T.; Alejos-De La Fuente, J.I.; Sosa-Ramírez, J.; Rangel-Muñoz, E.J. Aspergillus flavus and total aflatoxins occurrence in dairy feed and aflatoxin M1 in bovine milk in Aguascalientes, Mexico. Toxins 2022, 14, 292. [Google Scholar] [CrossRef] [PubMed]
- Chhaya, R.S.; O‘Brien, J.; Nag, R.; Cummins, E. Prevalence and concentration of mycotoxins in bovine feed and feed components: A global systematic review and meta-analysis. Sci. Total Environ. 2024, 929, 172323. [Google Scholar] [CrossRef]
- Hernandez-Valdivia, E.; Valdivia-Flores, A.G.; Cruz-Vazquez, C.; Martinez-Saldaña, M.C.; Quezada-Tristan, T.; Rangel-Muñoz, E.J.; Ortiz-Martínez, R.; Medina-Esparza, L.E.; Jaramillo-Juarez, F. Diagnosis of subclinical aflatoxicosis by biochemical changes in dairy cows under field conditions. Pak. Vet. J. 2021, 41, 33–38. [Google Scholar] [CrossRef] [PubMed]
- Benkerroum, N. Chronic and acute toxicities of aflatoxins: Mechanisms of action. Int. J. Environ. Res. Public Health 2020, 17, 423. [Google Scholar] [CrossRef]
- Jiang, Y.; Ogunade, I.M.; Vyas, D.; Adesogan, A.T. Aflatoxin in dairy cows: Toxicity, occurrence in feedstuffs and milk and dietary mitigation strategies. Toxins 2021, 13, 283. [Google Scholar] [CrossRef] [PubMed]
- EUM-SS Gobierno de los Estados Unidos Mexicanos (EUM). Secretaría de Salud (SS). Norma Oficial Mexicana NOM-188-SSA1-2002, Productos y Servicios. Control de Aflatoxinas en Cereales Para Consumo Humano y Animal. Especificaciones Sanitarias. Diario Oficial de la Federación, Primera Sección. 2002. Available online: https://www.dof.gob.mx/nota_detalle.php?codigo=719385&fecha=15/10/2002#gsc.tab=0 (accessed on 25 March 2024).
- EUM-SS Gobierno de los Estados Unidos Mexicanos. Secretaría de Salud. NOM-243-SSA1-2010, Productos y Servicios. Leche, Fórmula Láctea, Producto Lácteo Combinado y Derivados Lácteos. Disposiciones y Especificaciones Sanitarias. Métodos de Prueba. Diario Oficial de la Federación, Segunda Sección. 2010. Available online: https://www.dof.gob.mx/nota_detalle.php?codigo=5160755&fecha=27/09/2010#gsc.tab=0 (accessed on 5 February 2024).
- The Commission of the European Communities. Commission Directive 2003/100/EC of 31 October 2003 Amending Annex I to Directive 2002/32/EC of the European Parliament and of the Council on Undesirable Substances in Animal Feed. Off. J. Eur. Union 2003, 285, 33–37. Available online: https://www.legislation.gov.uk/eudr/2003/100/adopted (accessed on 20 February 2024).
- Commission Regulation (EU) No 165/2010 of 26 February 2010 amending Regulation (EC) No 1881/2006 Setting Maximum Levels for Certain Contaminants in Foodstuffs as Regards Aflatoxins. Off. J. Eur. Union 2010, 50, 8–12. Available online: https://eur-lex.europa.eu/legal-content/EN/TXT/PDF/?uri=CELEX:32010R0165 (accessed on 29 March 2024).
- Alvarez, C.L.; Azcarate, M.P.; Pinto, V.F. Toxigenic potential of Fusarium graminearum sensu stricto isolates from wheat in Argentina. Int. J. Food Microbiol. 2009, 135, 2. [Google Scholar] [CrossRef] [PubMed]
- Nikitin, D.A.; Ivanova, E.A.; Semenov, M.V.; Zhelezova, A.D.; Ksenofontova, N.A.; Tkhakakhova, A.K.; Kholodov, V.A. Diversity, ecological characteristics and identification of some problematic phytopathogenic Fusarium in Soil: A Review. Diversity 2023, 15, 49. [Google Scholar] [CrossRef]
- Rai, A.; Das, M.; Tripathi, A. Occurrence and toxicity of a Fusarium mycotoxin, zearalenone. Crit. Rev. Food Sci. Nutr. 2020, 60, 2710–2729. [Google Scholar] [CrossRef] [PubMed]
- Mahato, D.K.; Devi, S.; Pandhi, S.; Sharma, B.; Maurya, K.K.; Mishra, S.; Dhawan, K.; Selvakumar, R.; Kamle, M.; Mishra, A.K.; et al. Occurrence, impact on agriculture, human health, and management strategies of zearalenone in food and feed: A review. Toxins 2021, 13, 92. [Google Scholar] [CrossRef] [PubMed]
- Gagkaeva, T.; Gavrilova, O.; Orina, A.; Lebedin, Y.; Shanin, I.; Petukhov, P.; Eremin, S. Analysis of toxigenic Fusarium species associated with wheat grain from three regions of Russia: Volga, Ural, and West Siberia. Toxins 2019, 11, 5–252. [Google Scholar] [CrossRef] [PubMed]
- Qin, P.W.; Xu, J.; Jiang, Y.; Hu, L.; Van Der Lee, T.; Waalwijk, C.; Zhang, W.M.; Xu, X.D. Survey for toxigenic Fusarium species on maize kernels in China. World Mycotoxin J. 2020, 13, 2. [Google Scholar] [CrossRef]
- Gallo, A.; Mosconi, M.; Trevisi, E.; Santos, R.R. Adverse Effects of Fusarium Toxins in Ruminants: A Review of In Vivo and In Vitro Studies. Dairy 2022, 3, 474–499. [Google Scholar] [CrossRef]
- Kinkade, C.W.; Rivera-Núñez, Z.; Gorcyzca, L.; Aleksunes, L.M.; Barrett, E.S. Impact of Fusarium-derived mycoestrogens on female reproduction: A systematic review. Toxins 2021, 13, 373. [Google Scholar] [CrossRef] [PubMed]
- Hof, H. The medical relevance of Fusarium spp. J. Fungi 2020, 6, 117. [Google Scholar] [CrossRef]
- Nagl, V.; Grenier, B.; Pinton, P.; Ruczizka, U.; Dippel, M.; Bünger, M.; Oswald, I.P.; Soler, L. Exposure to zearalenone leads to metabolic disruption and changes in circulating adipokines concentrations in pigs. Toxins 2021, 13, 790. [Google Scholar] [CrossRef]
- Ropejko, K.; Twarużek, M. Zearalenone and its metabolites—General overview, occurrence, and toxicity. Toxins 2021, 13, 35. [Google Scholar] [CrossRef] [PubMed]
- Mesterhazy, A. Food safety aspects of breeding maize to multi-resistance against the major (Fusarium graminearum, F. verticillioides, Aspergillus flavus) and minor toxigenic fungi (Fusarium spp.) as well as to toxin accumulation, trends, and solutions—A Review. J. Fungi 2024, 10, 40. [Google Scholar] [CrossRef] [PubMed]
- Dogan, V.; Dal, S.D. Negative effects of zearalenone on reproductive productivity in dairy cattle. Vet. J. KU 2022, 1, 42–57. Available online: https://dergipark.org.tr/en/pub/vetjku/issue/71325/1146433 (accessed on 5 February 2024).
- Minervini, F.; Dell’Aquila, M.E.; Maritato, F.; Minoia, P.; Visconti, A. Toxic effects of the mycotoxin zearalenone and its derivatives on in vitro maturation of bovine oocytes and 17β-estradiol levels in mural granulosa cell cultures. Toxicol. Vitr. 2001, 15, 489–495. [Google Scholar] [CrossRef] [PubMed]
- Metzler, M.; Pfeiffer, E.; Hildebrand, A. Zearalenone and its metabolites as endocrine disrupting chemicals. World Mycotoxin J. 2010, 3, 385–401. [Google Scholar] [CrossRef]
- Wu, X.; Guo, L.; Huang, G.; Tang, W.; Zhao, S.; Wang, J.; Zhang, Y. Effects of dietary natural mycotoxins exposure on performance, biochemical parameters and milk small molecule metabolic pathways of lactating cows. Agriculture 2022, 12, 420. [Google Scholar] [CrossRef]
- Kemboi, D.C.; Antonissen, G.; Ochieng, P.E.; Croubels, S.; Okoth, S.; Kangethe, E.K.; Gathumbi, J.K. A review of the impact of mycotoxins on dairy cattle health: Challenges for food safety and dairy production in sub-Saharan Africa. Toxins 2020, 12, 222. [Google Scholar] [CrossRef] [PubMed]
- Geden, C.J.; Nayduch, D.; Scott, J.G.; Burgess IV, E.R.; Gerry, A.C.; Kaufman, P.E.; Thomson, J.; Pickens, V.; Machtinger, E.T. House fly (Diptera: Muscidae): Biology, pest status, current management prospects, and research needs. J. Integr. Pest Manag. 2021, 12, 39. [Google Scholar] [CrossRef]
- Nayduch, D.; Neupane, S.; Pickens, V.; Purvis, T.; Olds, C. House flies are underappreciated yet important reservoirs and vectors of microbial threats to animal and human health. Microorganisms 2023, 11, 583. [Google Scholar] [CrossRef]
- Khan, H.A.A.; Shad, S.A.; Akram, W. Effect of livestock manures on the fitness of house fly, Musca domestica L. (Diptera: Muscidae). Parasitol. Res. 2012, 111, 1165–1171. [Google Scholar] [CrossRef]
- de Jonge, N.; Michaelsen, T.Y.; Ejbye-Ernst, R.; Jensen, A.; Nielsen, M.E.; Bahrndorff, S.; Nielsen, J.L. Housefly (Musca domestica L.) associated microbiota across different life stages. Sci. Rep. 2020, 10, 7842. [Google Scholar] [CrossRef] [PubMed]
- Nayduch, D.; Burrus, R.G. Flourishing in filth: House fly–microbe interactions across life history. Annu. Rev. Entomol. 2017, 110, 6–18. [Google Scholar] [CrossRef]
- Sukontason, K.L.; Bunchu, N.; Methanitikorn, R.; Chaiwong, T.; Kuntalue, B.; Sukontason, K. Ultrastructure of adhesive device in fly in families calliphoridae, muscidae and sarcophagidae, and their implication as mechanical carriers of pathogens. Parasitol. Res. 2006, 98, 477–481. [Google Scholar] [CrossRef] [PubMed]
- Bahrndorff, S.; Ruiz-González, A.; de Jonge, N.; Nielsen, J.L.; Skovgård, H.; Pertoldi, C. Integrated genome-wide investigations of the housefly, a global vector of diseases reveal unique dispersal patterns and bacterial communities across farms. BMC Genom. 2020, 21, 66. [Google Scholar] [CrossRef] [PubMed]
- Balaraman, V.; Drolet, B.S.; Mitzel, D.N.; Wilson, W.C.; Owens, J.; Gaudreault, N.N.; Meekins, D.A.; Bold, D.; Trujillo, J.D.; Noronha, L.E.; et al. Mechanical transmission of SARS-CoV-2 by house flies. Parasit. Vectors 2021, 14, 214. [Google Scholar] [CrossRef] [PubMed]
- Patel, A.; Jenkins, M.; Rhoden, K.; Barnes, A.N. A systematic review of zoonotic enteric parasites carried by flies, cockroaches, and dung beetles. Pathogens 2022, 11, 90. [Google Scholar] [CrossRef] [PubMed]
- Khamesipour, F.; Lankarani, K.B.; Honarvar, B.; Kwenti, T.E. A systematic review of human pathogens carried by the housefly (Musca domestica L.). BMC Public Health 2018, 18, 1049. [Google Scholar] [CrossRef] [PubMed]
- Förster, M.; Klimpel, S.; Mehlhorn, H.; Sievert, K.; Messler, S.; Pfeffer, K. Pilot study on synanthropic flies (eg Musca, Sarcophaga, Calliphora, Fannia, Lucilia, Stomoxys) as vectors of pathogenic microorganisms. Parasitol. Res. 2007, 101, 243–246. [Google Scholar] [CrossRef] [PubMed]
- Srivoramas, T.; Chaiwong, T.; Sanford, M.R. Isolation of fungi from adult house fly, Musca domestica and the blow fly Chrysomya megacephala in Ubon Ratchathani province, northeastern Thailand. Int. J. Parasitol. Res. 2012, 4, 53–56. [Google Scholar] [CrossRef]
- Phoku, J.Z.; Barnard, T.G.; Potgieter, N.; Dutton, M.F. Mycotoxigenic potentials of the genera: Aspergillus, Fusarium and Penicillium isolated from houseflies (Musca domestica L.). Acta Trop. 2017, 168, 29–36. [Google Scholar] [CrossRef]
- Zingales, V.; Taroncher, M.; Martino, P.A.; Ruiz, M.J.; Caloni, F. Climate change and effects on molds and mycotoxins. Toxins 2022, 14, 445. [Google Scholar] [CrossRef] [PubMed]
- Kos, J.; Anić, M.; Radić, B.; Zadravec, M.; Hajnal, E.J.; Pleadin, J. Climate change—A global threat resulting in increasing mycotoxin occurrence. Foods 2023, 12, 2704. [Google Scholar] [CrossRef] [PubMed]
- Duchenne-Moutien, R.A.; Neetoo, H. Climate change and emerging food safety issues: A review. J. Food Prot. 2021, 84, 1884–1897. [Google Scholar] [CrossRef]
- Cruz-Vázquez, C.; Vital-Gutiérrez, J.; Medina-Esparza, L.; Ortega-Mora, L.; Valdivia-Flores, A.; Quezada-Tristán, T.; Orihuela-Trujillo, A. Neospora caninum infection during the first gestation of Holstein heifers that consume food contaminated naturally with zearalenone under field conditions. Iran. J. Parasitol. 2017, 12, 563–571. Available online: https://ijpa.tums.ac.ir/index.php/ijpa/article/view/1930 (accessed on 22 April 2024). [PubMed]
- Rangel-Muñoz, E.J.; Cruz-Vázquez, C.; Medina-Esparza, L.; Vitela-Mendoza, I.; Valdivia-Flores, A.G. Presence of the toxigenic fungi Aspergillus spp. and Fusarium spp. in Musca domestica L. (Diptera: Muscidae) collected from dairy farms. J. Dairy Sci. 2023, 106, 5468–5473. [Google Scholar] [CrossRef] [PubMed]
- Gerry, A.C. Review of methods to monitor house fly (Musca domestica) abundance and activity. J. Econ. Entomol. 2020, 113, 2571–2580. [Google Scholar] [CrossRef] [PubMed]
- Yin, J.H.; Kelly, P.J.; Wang, C. Flies as vectors and potential sentinels for bacterial pathogens and antimicrobial resistance: A review. Vet. Sci. 2022, 9, 300. [Google Scholar] [CrossRef] [PubMed]
- Sales, M.d.S.N.; Costa, G.L.d.; Bittencourt, V.R.E.P. Isolation of fungi in Musca domestica Linnaeus, 1758 (Diptera: Muscidae) captured at two natural breeding grounds in the municipality of Seropédica, Rio de Janeiro, Brazil. Mem. Inst. Oswaldo Cruz 2002, 97, 1107–1110. [Google Scholar] [CrossRef] [PubMed]
- Puga-Torres, B.; Cáceres-Chicó, M.; Alarcón-Vásconez, D.; Gómez, C. Determination of zearalenone in raw milk from different provinces of Ecuador. Vet. World 2021, 14, 2048–2054. [Google Scholar] [CrossRef]
- Cruz-Vazquez, C.; Vitela-Mendoza, I.; Ramos-Parra, M.; García-Vazquez, Z. Influence of temperature, humidity and rainfall on field population trend of Stomoxys calcitrans (Diptera: Muscidae) in a semiarid climate in Mexico. Parasitol. Latinoam. 2004, 59, 99–103. [Google Scholar] [CrossRef]
- Meraz-Jiménez, A.D.J.; López-Santos, A.; García-Munguía, C.A.; Torres-González, J.A.; García Munguía, A.M. Potential distribution of Musca domestica in Jesús María Municipality, Aguascalientes, Mexico, based on climate change scenarios. Rev. Mex. Cienc. Pecu. 2019, 10, 14–29. [Google Scholar] [CrossRef]
- INEGI Instituto Nacional de Estadística y Geografía. Available online: https://www.inegi.org.mx/app/areasgeograficas/?ag=07000001#collapse-Resumen (accessed on 29 March 2024).
- INIFAP Instituto Nacional de Investigaciones Forestales, Agrícolas y Pecuarias. Available online: https://clima.inifap.gob.mx/lnmysr/Estaciones/Mapa (accessed on 29 February 2024).
- Kassiri, H.; Zarrin, M.; Veys-Behbahani, R.; Faramarzi, S.; Kasiri, A. Isolation and identification of pathogenic filamentous fungi and yeasts from adult house fly (Diptera: Muscidae) captured from the hospital environments in Ahvaz City, southwestern Iran. J. Med. Entomol. 2015, 52, 1351–1356. [Google Scholar] [CrossRef] [PubMed]
- Acharya, T.; Hare, J. Sabouraud agar and other fungal growth media. In Laboratory Protocols in Fungal Biology; Gupta, V.K., Tuohy, M., Eds.; Springer: Cham, Switzerland, 2022. [Google Scholar] [CrossRef]
- Pereira, V.J.; Fernandes, D.; Carvalho, G.; Benoliel, M.J.; San Romão, M.V.; Crespo, M.B. Assessment of the presence and dynamics of fungi in drinking water sources using cultural and molecular methods. Water Res. 2010, 44, 4850–4859. [Google Scholar] [CrossRef] [PubMed]
- Ángel-Sahagún, C.A.; Lezama, R.; Molina, J.; Pescador, A.; Skoda, S.R.; Cruz-Vázquez, C.; Foster, J.E. Virulence of Mexican isolates of entomopathogenic fungi upon Rhipicephalus microplus larvae and the efficacy of conidia formulations to reduce larval tick density under field conditions. Vet. Parasitol. 2010, 170, 278–286. [Google Scholar] [CrossRef]
- Klich, M.A. Identification of Common Aspergillus Species, 1st ed.; Centraalbureau voor Schimmelcultures: Utrecht, The Netherlands, 2002. [Google Scholar]
- Leslie, J.F.; Summerell, B.A. The Fusarium Laboratory Manual; John Wiley and Sons: Hoboken, NJ, USA, 2008. [Google Scholar]

| Location | Number 1 | Dry Season 2 | Wet Season 2 | ||
|---|---|---|---|---|---|
| Flies | Fungi | Flies | Fungi | ||
| Dairy Farm | |||||
| I | 7 | 6.3 c ± 0.6 | 2.0 b ± 0.49 | 17.1 d ± 1.4 ** | 4.1 c ± 0.3 ns |
| II | 7 | 6.4 c ± 0.7 | 0.6 b ± 0.19 | 20.7 d ± 2.0 ** | 4.3 c ± 0.7 * |
| III | 7 | 23.4 bc ± 2.8 | 5.3 ab ± 0.59 | 72.6 cd ± 12.2 ** | 5.6 c ± 0.5 ns |
| IV | 7 | 19.3 bc ± 0.9 | 1.6 b ± 0.43 | 72.9 cd ± 8.5 ns | 10.0 c ± 1.2 ** |
| V | 7 | 15.3 c ± 1.7 | 3.6 b ± 0.54 | 88.4 cd ± 9.6 ** | 13.3 c ± 1.4 ** |
| VI | 7 | 25.6 bc ± 4.5 | 4.4 ab ± 0.64 | 125 cd ± 23.3 ** | 15.9 c ± 2.1 * |
| VII | 7 | 49.4 c ± 6.7 | 2.4 ab ± 0.33 | 143 cd ± 12.4 ** | 42.3 c ± 3.8 ** |
| VIII | 7 | 178 a ± 10.3 | 5.1 ab ± 1.19 | 178 c ± 28.5 ns | 48.9 c ± 4.0 ** |
| IX | 7 | 19.0 bc ± 1.3 | 4.9 ab ± 0.61 | 551 b ± 40.7 ** | 156 b ± 8.6 ** |
| X | 7 | 111 b ± 16.8 | 8.7 a ± 1.19 | 1038 a ± 66.7 ** | 383 a ± 23.7 ** |
| Site | |||||
| Feeders (Low) | 10 | 38.2 b ± 11.6 | 2.5 b ± 0.5 | 172 a ± 61.2 * | 56.2 a ± 12.0 * |
| Feeders (Middle) | 10 | 50.9 b ± 13.5 | 2.8 b ± 0.6 | 238 a ± 66.0 ** | 48.8 a ± 9.1 * |
| Feeders (High) | 10 | 43.6 b ± 9.9 | 3.4 b ± 0.5 | 233 a ± 60.6 ** | 69.2 a ± 11.8 ** |
| Rearing room | 10 | 47.1 b ± 14.0 | 1.6 b ± 0.4 | 285 a ± 74.8 ** | 63.0 a ± 9.7 ** |
| Milking parlor | 10 | 58.5 a ± 18.8 | 4.1 a ± 0.9 | 226 a ± 97.5 ns | 65.4 a ± 16.8 ns |
| Silo-cutting surface | 10 | 40.2 b ± 8.2 | 8.0 b ± 0.5 | 217 a ± 50.7 ** | 83.1 a ± 16.8 * |
| Feed store | 10 | 38.6 b ± 14.2 | 4.6 a ± 0.6 | 242 a ± 92.0 * | 92.4 a ± 21.7 * |
| All | 70 | 45.3 ± 12.9 | 3.9 ± 0.6 | 231 ± 71.8 *** | 68.3 ± 14.0 *** |
| Location | Number 1 | Dry Season 2 | Wet Season 2 | ||
|---|---|---|---|---|---|
| Aspergillus | Fusarium | Aspergillus | Fusarium | ||
| Dairy Farm | |||||
| I | 7 | 0.6 b ± 0.1 | 0.6 b ± 0.2 | 0.0 b ± 0.0 * | 1.3 b ± 0.2 ns |
| II | 7 | 0.0 b ± 0.0 | 0.0 b ± 0.0 | 0.7 b ± 0.2 ns | 0.1 b ± 0.1 ns |
| III | 7 | 0.7 b ± 0.2 | 2.0 ab ± 0.3 | 0.4 b ± 0.2 ns | 0.7 b ± 0.2 ns |
| IV | 7 | 1.1 b ± 0.3 | 0.3 b ± 0.1 | 0.1 b ± 0.1 ns | 1.3 b ± 0.3 ns |
| V | 7 | 1.7 b ± 0.5 | 1.9 ab ± 0.4 | 0.0 b ± 0.0 ns | 3.6 b ± 0.7 ns |
| VI | 7 | 0.3 b ± 0.1 | 0.3 b ± 0.1 | 0.0 b ± 0.0 ns | 7.3 b ± 1.1 ** |
| VII | 7 | 0.6 b ± 0.2 | 1.1 ab ± 0.3 | 6.1 b ± 1.0 * | 4.9 b ± 1.2 ns |
| VIII | 7 | 0.0 b ± 0.0 | 4.4 a ± 1.0 | 10.3 b ± 1.9 * | 7.4 b ± 1.2 ns |
| IX | 7 | 0.6 b ± 0.2 | 1.4 ab ± 0.3 | 5.3 b ± 1.8 ns | 53.7 a ± 6.4 ** |
| X | 7 | 6.1 a ± 0.8 | 0.3 b ± 0.1 | 63.9 a ± 8.4 ** | 89.9 a ± 13.8 ** |
| Site | |||||
| Feeders (Low) | 10 | 0.9 a ± 0.2 | 0.2 a ± 0.1 | 12.1 a ± 3.5 ns | 0.4 a ± 0.2 ns |
| Feeders (Middle) | 10 | 0.2 a ± 0.1 | 0.6 a ± 0.2 | 1.5 a ± 0.6 * | 7.9 a ± 2.4 * |
| Feeders (High) | 10 | 0.2 a ± 0.1 | 2.0 b ± 0.5 | 11.4 a ± 3.0 ns | 20.5 a ± 3.7 * |
| Rearing room | 10 | 0.8 a ± 0.2 | 0.1 a ± 0.1 | 6.8 a ± 2.0 ns | 8.8 a ± 1.8 * |
| Milking parlor | 10 | 1.9 a ± 0.6 | 1.1 a ± 0.3 | 12.5 a ± 5.3 ns | 29.1 a ± 7.2 ns |
| Silo-cutting surface | 10 | 3.3 a ± 0.5 | 2.8 a ± 0.5 | 9.9 a ± 3.0 ns | 24.6 a ± 5.3 * |
| Feed store | 10 | 0.9 a ± 0.2 | 1.8 a ± 0.4 | 6.6 a ± 2.4 ns | 27.8 a ± 8.9 ns |
| All | 70 | 1.2 b ± 0.3 | 1.2 b ± 0.3 | 8.7 a ± 2.8 *** | 17.0 a ± 4.2 *** |
| AFs or ZEA-producing (No.) | 70 | 0.3 ± 0.1 | 1.9 ± 0.6 | 5.5 ± 0.7 *** | 7.2 ± 0.8 *** |
| AFs or ZEA-producing (%) | 70 | 32.9 | 22.6 | 79.3 | 42.5 |
| Mycotoxins (AFs or ZEA, µg/kg) | 70 | 327 ± 145 | 3132 ± 1772 | 655 ± 98.8 ns | 1909 ± 817 ns |
| Factor | House Flies | Fungi Isolations | Aspergillus | Fusarium | AFs-Producing Aspergillus spp. | ZEA-Producing Fusarium spp. |
|---|---|---|---|---|---|---|
| Model | 0.0000 | 0.0000 | 0.0000 | 0.0000 | 0.0000 | 0.0000 |
| Station | 0.0003 | 0.0000 | 0.0099 | 0.0095 | 0.0154 | 0.0060 |
| Dairy farm | 0.0000 | 0.0000 | 0.0000 | 0.0000 | 0.0000 | 0.0000 |
| Site (DF) | 0.9249 | 0.9816 | 0.9539 | 0.5305 | 0.9996 | 0.0025 |
| Pluvial precipitation | 0.0000 | 0.0000 | 0.0002 | 0.0001 | 0.0001 | 0.0000 |
| Relative humidity | 0.0010 | 0.0004 | 0.0397 | 0.0251 | 0.0553 | 0.0156 |
| Coefficient of determination R2 (%) | 74.4 | 67.0 | 46.4 | 46.6 | 42.5 | 53.7 |
| Correlation coefficient with trapped houseflies (*** p-value < 0.001) | -- | 0.887 *** | 0.617 *** | 0.691 *** | 0.630 *** | 0.641 *** |
| Meteorological Variables | A. Dry Season | B. Wet Season | Mean Increase | ||
|---|---|---|---|---|---|
| Mean | STD | Mean | STD | (B − A)/A% | |
| Pluvial precipitation (mm/mo) | 0.24 b | ±0.37 | 48.3 b | ±31.6 | 20,025 |
| Relative humidity (%) | 43.0 b | ±5.6 | 67.7 b | ±1.44 | 57.4 |
| Middle temperature (°C) | 18.4 b | ±0.64 | 19.5 b | ±0.06 | 6.0 |
| Maximum temperature (°C) | 28.3 b | ±0.69 | 26.1 b | ±0.14 | −7.8 |
| Minimum temperature (°C) | 8.5 b | ±1.41 | 13.0 b | ±0.21 | 52.9 |
Disclaimer/Publisher’s Note: The statements, opinions and data contained in all publications are solely those of the individual author(s) and contributor(s) and not of MDPI and/or the editor(s). MDPI and/or the editor(s) disclaim responsibility for any injury to people or property resulting from any ideas, methods, instructions or products referred to in the content. |
© 2024 by the authors. Licensee MDPI, Basel, Switzerland. This article is an open access article distributed under the terms and conditions of the Creative Commons Attribution (CC BY) license (https://creativecommons.org/licenses/by/4.0/).
Share and Cite
Rangel-Muñoz, E.J.; Valdivia-Flores, A.G.; Cruz-Vázquez, C.; de-Luna-López, M.C.; Hernández-Valdivia, E.; Vitela-Mendoza, I.; Medina-Esparza, L.; Quezada-Tristán, T. Increased Dissemination of Aflatoxin- and Zearalenone-Producing Aspergillus spp. and Fusarium spp. during Wet Season via Houseflies on Dairy Farms in Aguascalientes, Mexico. Toxins 2024, 16, 302. https://doi.org/10.3390/toxins16070302
Rangel-Muñoz EJ, Valdivia-Flores AG, Cruz-Vázquez C, de-Luna-López MC, Hernández-Valdivia E, Vitela-Mendoza I, Medina-Esparza L, Quezada-Tristán T. Increased Dissemination of Aflatoxin- and Zearalenone-Producing Aspergillus spp. and Fusarium spp. during Wet Season via Houseflies on Dairy Farms in Aguascalientes, Mexico. Toxins. 2024; 16(7):302. https://doi.org/10.3390/toxins16070302
Chicago/Turabian StyleRangel-Muñoz, Erika Janet, Arturo Gerardo Valdivia-Flores, Carlos Cruz-Vázquez, María Carolina de-Luna-López, Emmanuel Hernández-Valdivia, Irene Vitela-Mendoza, Leticia Medina-Esparza, and Teódulo Quezada-Tristán. 2024. "Increased Dissemination of Aflatoxin- and Zearalenone-Producing Aspergillus spp. and Fusarium spp. during Wet Season via Houseflies on Dairy Farms in Aguascalientes, Mexico" Toxins 16, no. 7: 302. https://doi.org/10.3390/toxins16070302
APA StyleRangel-Muñoz, E. J., Valdivia-Flores, A. G., Cruz-Vázquez, C., de-Luna-López, M. C., Hernández-Valdivia, E., Vitela-Mendoza, I., Medina-Esparza, L., & Quezada-Tristán, T. (2024). Increased Dissemination of Aflatoxin- and Zearalenone-Producing Aspergillus spp. and Fusarium spp. during Wet Season via Houseflies on Dairy Farms in Aguascalientes, Mexico. Toxins, 16(7), 302. https://doi.org/10.3390/toxins16070302








